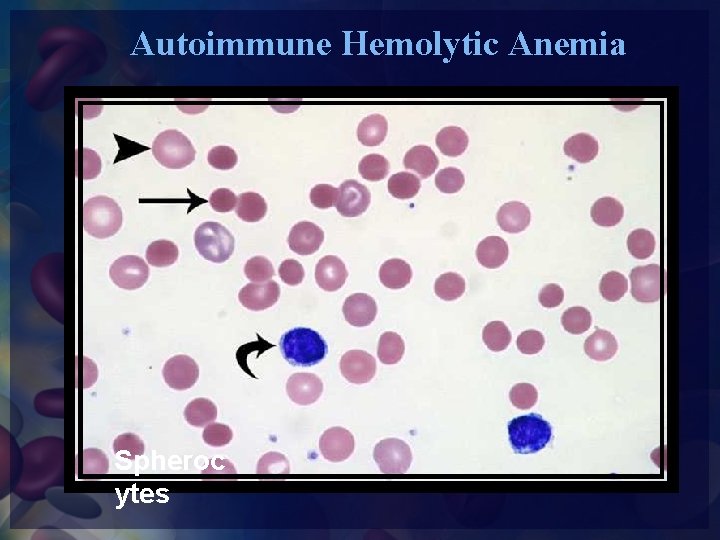
Autoimmune Hemolytic Anemia Spheroc ytes
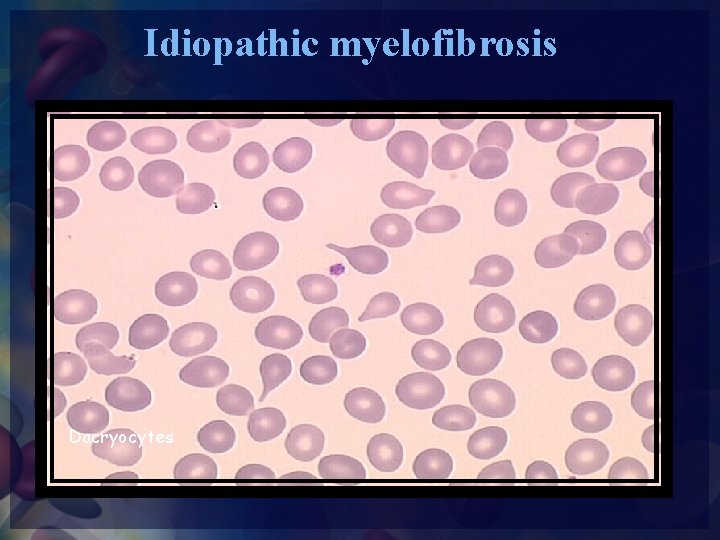
Idiopathic myelofibrosis Dacryocytes

Practical Hematology Lab LAB 2 RBCs Morphology RBCS

Practical Hematology Lab - LAB 2 - RBC’s Morphology

RBCS Abnormal Morphology Peripheral Blood Morphology

RECORDING RBC MORPHOLOGY 1. Scan area using × 100 (oil immersion). 2. Observe 10 fields. 3. Red cells are observed for size, shape, hemoglobin content, and the presence or absence of inclusions. 4. Abnormal morphology: Red cell morphology is assessed according to See the following sample grading system. Note that red cell morphology must be scanned in a good counting area. Two questions should be asked 1. Is the morphology seen in every field? 2. Is the morphology pathologic and not artificially induced?

Abnormal Erythrocyte Morphology Is found in pathological states that may be abnormalities in I. Red cell distribution. II. Size (anisocytosis). III. Hemoglobin content – Color Variation. IV. Shape (poikilocytosis). V. The presence of inclusion bodies in erythrocyte.

I. Erythrocyte Distribution Abnormalities Rouleaux formation Stacking of RBCs due to increased plasma proteins coating RBCs (resembling a stack of coins) Found in • Hyperfibrinogenaemia • Hyperglobulinaemia

Agglutination Antibody-mediated Irregular clumping , temperature dependent Found in • Cold agglutinins • Warm autoimmune hemolysis


Rouloux Formation Agglutination

II. Variation In Erythrocyte Size (Anisocytosis) Anisocytosis Variations in size (Microcyte and Macrocyte) Normocytic RBC’s Normal size of RBC (8 μm) with a range of 7 to 9 μm. The nucleus of a small lymphocyte (± 8 µm) is a useful guide to the size of a red blood cell).

Microcytic RBC cell smaller than the normal RBC ( <7 μm), and is associated with a decrease in hemoglobin synthesis Found in • Iron deficiency anemia. • Thalassaemia. • Sideroblastic anemia. • Lead poisoning. • Anemia of chronic disease.

Macrocyte RBC larger than the normal (>9 μm) and is the result of a defect in nuclear maturation or stimulated erythropoiesis. May be round or oval in shape, the diagnostic significance being different. Found in • Folate and B 12 deficiencies (oval) • Ethanol (round) • Liver disease (round) • Reticulocytosis (round)

Example : Film Study Most erythrocytes presented in the picture are microcytes (compare with the small lymphocyte). The degree of hemoglobinization is sufficient. Normal platelets and single ovalocytes are present. 1. Microcyte 2. Normocyte

III. Variation In Erythrocyte Color • A normal erythrocyte has a pinkish-red color with a slightly lighter-colored center (central pallor) when stained with a blood stain, such as Wright. • The color of the erythrocyte is representative of hemoglobin concentration in the cell. • Under normal conditions, when the color, central pallor, and hemoglobin are proportional, the erythrocyte is referred to as Normochromic.

Hypochromia • Increased central pallor and decreased hemoglobin concentration, the central pallor occupies more than the normal third of the red cell diameter. Found in • Iron deficiency • Thalassaemia • any of the conditions leading to Microcytosis

Polychromasia • Red cells stain shades of blue-gray as a consequence of uptake of both eosin (by hemoglobin) and basic dyes (by residual ribosomal RNA). Often slightly larger than normal red cells and round in shape - round macrocytosis. Found in Any situation with reticulocytosis – for example bleeding, hemolysis or response to heamatinic factor replacement.

What Abnormal Results Mean This test is used to diagnose the cause of anemia. The following are the types of anemia and their causes: • Normocytic/ normochromic (NC/NC) anemia is caused by sudden blood loss, prosthetic heart valves, sepsis, tumor, long-term disease or aplastic anemia. • Microcytic/ hypochromic anemia is caused by iron deficiency, lead poisoning, or thalassemia. • Microcytic/ normochromic anemia results from a deficiency of the hormone erythropoietin from kidney failure. • Macrocytic /normochromic anemia results from chemotherapy, folate deficiency, or vitamin B-12 deficiency.

IV. Shape Abnormalities of Erythrocytes • Poikilocytosis is the general term for mature erythrocytes that have a shape other than the round, biconcave disk. • Poikilocytes can be seen in many shapes. (e. g. Acanthocyte, Spherocytosis, …)

Shape Abnormalities of Erythrocytes Terminology Description Condition Target Cells Central Hemoglobin; target shaped Liver Disease; Thalassaemia, Abnormal Hb; Iron Deficiency Echinocyte Short specula's, equallyspaced Uremia, Hypokalemia, Artifact Acanthocyte Speculated, Irregular Liver disease (Alcohol), Postspleenoctomy. Spherocyte Spherical, no central pallor HS, immune Hemolytic anemia Shistocyte Fragmented RBC, Helmet cells MAHA, burns Ovalocyte Oval / Elliptical shaped Hereditary elliptocytosis, Megaloblastic anemia. Sickle Cell Bipolar speculated shape “ banana” shaped Hb S-containing hemoglobinopathy Teardrop cell Single elongated extremity Myelophthistic changes Bite cells Irregular gap in membrane G 6 PD deficiency

Target cell Red cell with a “target” or bull’s-eye appearance. The cell appears with a central bull’s eye that is surrounded by a clear ring and then an outer red ring. Found in • • • Obstructive liver disease Severe iron deficiency Thalassaemia Post splenectomy Lipid disorders Haemoglobinopathies (S and C)

Spherocytosis Red cells are more spherical. Lack the central area of pallor on a stained blood film. Found in • Hereditary spherocytosis • Immune haemolytic anemia • Zieve's syndrome • Microangiopathic haemolytic

Stomatocyte Red cells with a central linear slit or stoma. Seen as mouthshaped form in peripheral smear. Found in • Alcohol excess • Alcoholic liver disease • Hereditary stomatocytosis

Ovalocyte An elongated oval cell. They are a result of a membrane defect. Found in • Thalassaemia major. • Hereditary ovalocytosis. • Sickle cell anemia

Elliptocyte The red cells are oval or elliptical in shape. Long axis is twice the short axis. Found in • Hereditary elliptocytosis • Megaloblastic anemia • Iron deficiency • Thalassaemia • Myelofibrosis

Schistocyte Red cell fragments that are irregular in shape and size. They are usually half the size of the normal RBC; therefore, they have a deeper red color. Found in • DIC • Micro angiopathic haemolytic anemia • Mechanical haemolytic anemia

Blister cell: pre keratocyte Have accentric hallow area. Resemble a women's handbag and may be called pocket-book cell. Found in Microangiopathic hemolytic anemia

Keratocytes (horn cell) Part of the cell fuses back leaving two or three horn-like projections. The keratocyte is a fragile cell and remains in circulation for only a few hours. Found in • Uraemia • Severe burns • EDTA artifact • Liver disease Also called helmet cells

Degmacyte "bite cell" • An abnormally shaped red blood cell with one or more semicircular portions removed from the cell margin. • These "bites" result from the removal of denatured hemoglobin by macrophages in the spleen. Found In • G-6 -PD deficiency, in which uncontrolled oxidative stress causes hemoglobin to denature and form Heinz bodies, is a common disorder that leads to the formation of bite cells.

Sickle Cells Sickle shaped red cells. Found in Hb-S disease and trait

Echinocyte “Burr” (crenation ) cell: Red cell with 30 or more, short blunt projections which are regularly distributed on their surface Found in Usually artifactual— the result of slow drying under humid conditions. Sometimes are non - artifactual, indicating uremia or pyruvate kinase deficiency. • Hemolytic anemia • Uremia. • Megaloblastic anemia Cells retain the central pallor.

Echinocytes (Burr Cells)

Acanthocytosis (Spur Cells): Red blood cells with irregularly spaced projections, these projections very in width but usually contain a rounded end Found in • Liver disease • Post splenectomy • Anorexia nervosa and starvation

Acanthocytes (Spur Cells)

Dacryocytes (Teardrop) Resembles a tear and usually smaller than the normal RBC. Found in • Bone marrow fibrosis • Megaloblastic anemia • Iron deficiency • Thalassaemia

Envelope Form Cell Found in • Thalassaemia • Sickle cell anemia

V. Erythrocyte Inclusions with Wright’s Stain Inclusion Composition Appearance Condition Basophilic stippling Precipitated ribosomes Evenly dispersed fine or coarse granules - Lead poisoning Thalassaemia , other anemia. Howell-Jolly bodies DNA in origin Nuclear Fragment Pappenheimer bodies Heinz bodies Dense, round blue Post – Splenectomy granule Iron-containing Small blue granules in clusters Denatured Hemoglobin Anemia's Round blue precipitates G 6 PD Cabot Rings Remnants of Reddish-blue thread Nuclear membrane like rings Severe anemia, Lead poisoning. Organism Small blue inclusion Malaria Babesiosis

Howell-Jolly Bodies Small round cytoplasmic red cell inclusion with same staining characteristics as nuclei Found in • Post splenectomy • Megaloblastic anemia

Siderotic Granules (Pappenheimer Bodies) These are iron containing granules in red blood cells that are seen because the iron is aggregated with mitochondria and ribosomes. They appear as faint violet or magenta specks, often in small clusters, due to staining of the associated protein. They are associated with severe anemias and thalassemias. Pappenheimer bodies can be increased in hemolytic anemia, infections and post-splenectomy.

Basophilic stippling Considerable numbers of small basophilic inclusions in red cells. Found in • Thalassaemia • Megaloblastic anemia • Hemolytic anemia • Liver disease • Heavy metal poisoning.

Heinz Bodies Represent denatured hemoglobin (methemoglobin - Fe+++) within a cell. With a supravital stain like crystal violet, Heinz bodies appear as round blue precipitates. Presence of Heinz bodies indicates red cell injury and is usually associated with G 6 PD-deficiency.

Heinz Body Preparation. RBC are incubated supravitally in new Methylene blue to identify precipitates of oxidatively denatured hemoglobin.

Cabot Rings Reddish-blue threadlike rings in RBCs of severe anemia's. These are remnants of the nuclear membrane or remnants of microtubules and appear as a ring or figure 8 pattern. Very rare finding in patients with • Megaloblastic anemia. • severe anemia's. • lead poisoning. • Dyserythropoiesis. A - Cabot ring B - Howell-Jolly body

Parasites of Red Cell Two organisms are have a tendency to invade the RBCs 1. All 4 species of the malaria parasite will invade RBCs. We will see the Plasmodium of different species in RBCs. 2. Theileria microti (Bebesia microti)

Malaria

RBCs Abnormal morphology Depiction of red blood cell morphologies that may appear on a peripheral smear, showing: (A)basophilic stippling, (B)Howell-Jolly bodies, (C)Cabot's ring bodies

RED BLOOD CELL MORPHOLOGY A normal red blood cell should be approximately the same size as a normal lymphocyte nucleus or 2 normal sized red blood cells should fit side by side across a normal sized poly (not a hypersegmented poly). NO. of Field/ Oil imm. Grade Degree of abnormality 1 -6 per oil imm. field 1+ 7 -10 per OIF 2+ 11 -20 per OIF 3+ > 20 per OIF 4+

REPORTING RESULTS Where possible use macrocytic and microcytic, rather than simply anisocytosis alone, when describing red cell morphology. Use specific cell morphology when possible, rather than simply reporting poikilocytosis. When red cells are normocytic, normochromic, report out as NORMAL. When abnormal morphology has been noted, DO NOT indicate normal on the report form. EXAMPLE: 7 -10 microcytic RBC's/OIF is reported out as: 2+ microcytosis or Moderate microcytosis.

Determine A Quantitative Scale 1

Grading Inclusions 2

Blood Film In Some Cases

Normal Peripheral Smear
Autoimmune Hemolytic Anemia Spheroc ytes

Hereditary Spherocytosis Spherocytes

Hereditary pyropoikilocytosis

Microangiopathic Hemolytic Anemia Schistocytes

Sickle Cell Anemia Hb SS
Idiopathic myelofibrosis Dacryocytes

Iron Deficiency Anemia Severe Hypochromia

Treated Iron Deficiency Anemia Mixed Population:

Alpha Thalassaemia (a-/--) Microcytic Hypochromia

Morphologic Changes in Liver Disease Target Cells Spur Cells

Hepatorenal Syndrome Burr + Spur Cells
- Slides: 61